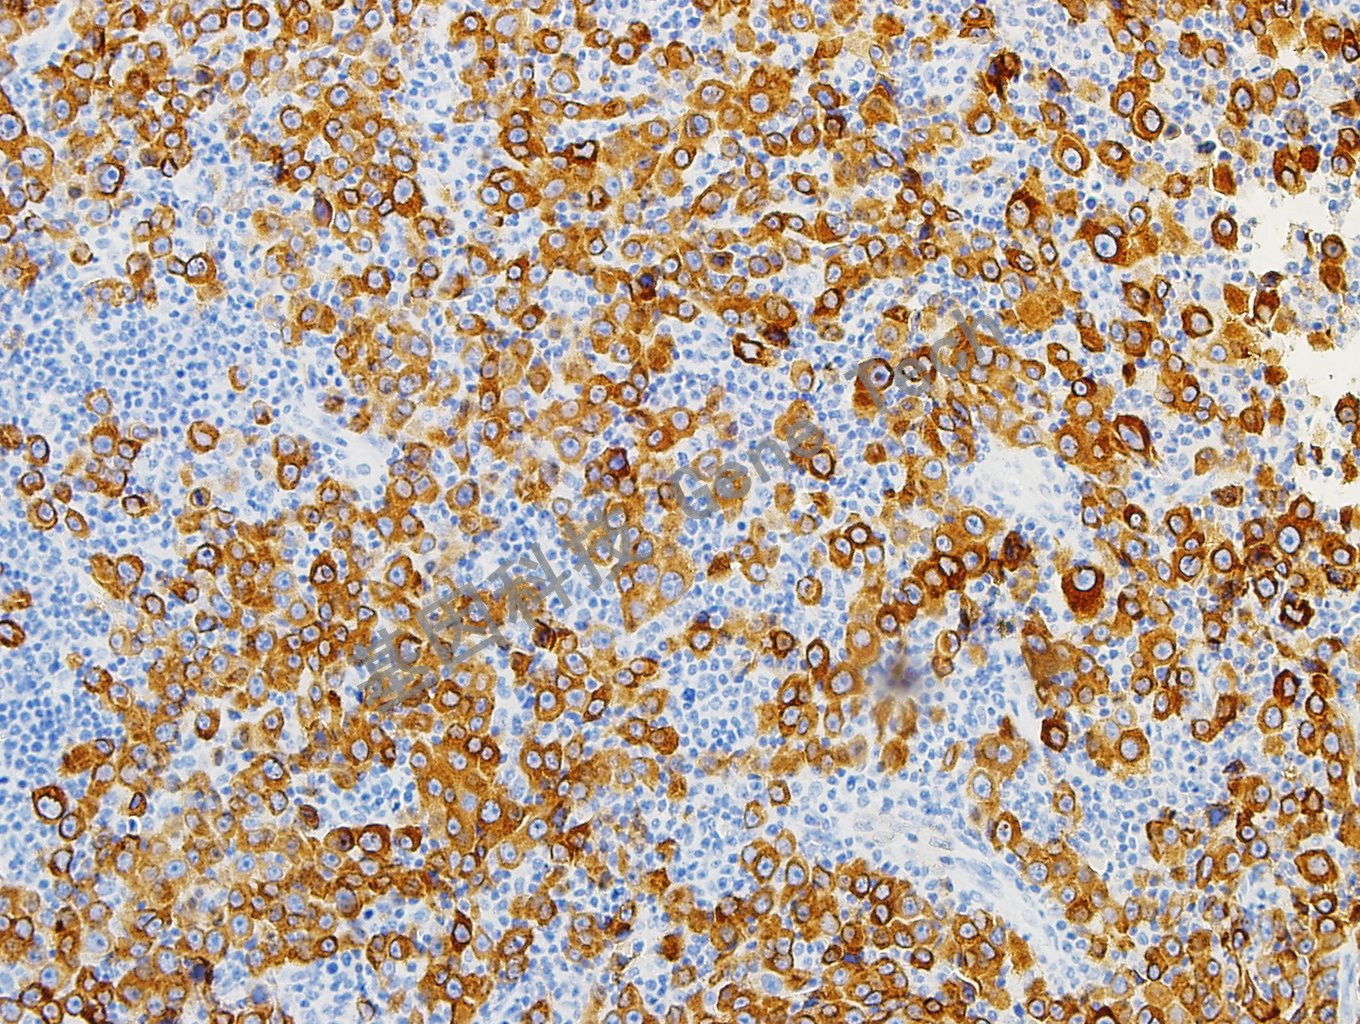
1683698800136863.jpg

產(chǎn)品中心
Products
免疫組織化學(xué)(IHC)
基因突變及甲基化檢測
熒光原位雜交(FISH)
原位雜交(ISH)
Melan-A 鼠抗人 MART-1/melan A 抗體試劑(免疫組織化學(xué))
瀏覽次數(shù):1718 發(fā)布時間:2019-12-16
| 滬閔械備20180057號 | ||
| 克隆號:A103 | 種屬:鼠 | 適用染色系統(tǒng):GTvisionTM |
| 預(yù)處理:高pH熱修復(fù) | 陽性部位:細(xì)胞漿 | 陽性對照:黑色素瘤 |
| 簡介:Melan-A又稱MART-1(M)是一種由118個氨基酸組成的跨膜蛋白,在90%以上的黑色素細(xì)胞及黑色素瘤中均有表達(dá)。此外,Melan-A也可表達(dá)于:腎上腺皮質(zhì)、腎上腺腺瘤及癌、卵巢門細(xì)胞、卵巢性索間質(zhì)腫瘤、睪丸支持細(xì)胞及血管平滑肌脂肪瘤等。該抗體主要用于黑色素瘤的診斷與研究。 | ||
![]() | ||
| 黑色素瘤石蠟切片,用 Melan-A(GM7196)染色,細(xì)胞漿陽性,DAB 顯色。 | ||
| 貨號 | GM719602 | GM719604 | GM719607 | GM719629 |
| 規(guī)格 | 2.0ml | 4.0ml | 7.0ml | 0.2ml濃縮液 |